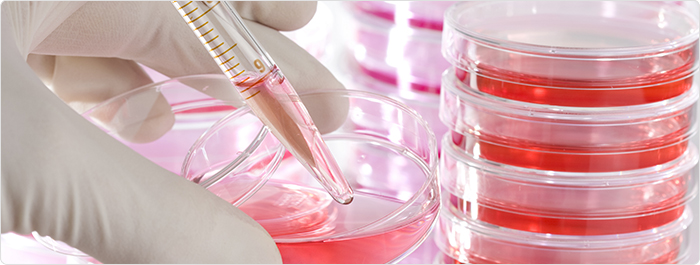

แอนแทรก (Anthrax)
- โดย ศาสตราจารย์เกียรติคุณ แพทย์หญิง พวงทอง ไกรพิบูลย์
- 26 มิถุนายน 2565
- Tweet
สารบัญ
- บทนำ: คือโรคอะไร? พบบ่อยไหม?
- แอนแทรกติดต่ออย่างไร? มีกลไกเกิดโรคอย่างไร?
- ใครมีปัจจัยเสี่ยงติดเชื้อแอนแทรก?
- แอนแทรกมีอาการอย่างไร?
- ควรพบแพทย์เมื่อไหร่?
- แพทย์วินิจฉัยแอนแทรกได้อย่างไร?
- รักษาแอนแทรกอย่างไร?
- แอนแทรกก่อผลข้างเคียงอย่างไร?
- ดูแลตนเองอย่างไร?
- ป้องกันแอนแทรกได้อย่างไร?
- บรรณานุกรม
บทความที่เกี่ยวข้อง
- โรคติดเชื้อ ภาวะติดเชื้อ (Infectious disease)
- แบคทีเรีย: โรคจากแบคทีเรีย (Bacterial infection)
- ไข้หวัดใหญ่ (Influenza)
- ยาปฏิชีวนะ (Antibiotics)
- ภาวะพิษเหตุติดเชื้อ (Sepsis) ภาวะติดเชื้อในกระแสเลือด (Septicemia)
- โมโนโคลนอลแอนตีบอดี (Monoclonal Antibodies)
- ภาวะช็อก อาการช็อก (Shock)
- โรคคล้ายไข้หวัดใหญ่ หรือ โรคอาการคล้ายไข้หวัดใหญ่ (Influenza-like illness: ILI)
บทนำ: คือโรคอะไร? พบบ่อยไหม?
แอนแทรก (Anthrax) คือ โรคติดเชื้อเฉียบพลันจากแบคทีเรียชนิดแกรมบวก ชื่อ ‘Bacillus anthracis’ พบน้อยทั่วโลก มีรายงานพบประมาณ 2,000 รายในแต่ละปี แต่เป็นโรคที่รุนแรง พบทุกเพศและทุกอายุ เป็นโรคที่ไม่สามารถติดต่อจากคนสู่คนได้
แอนแทรก เป็นโรคติดต่อจากสัตว์สู่คน (Zoonotic disease หรือ Zoonosis) โดยคนติดเชื้อจากสัตว์ที่ติดเชื้อแอนแทรก ซึ่งโดยทั่วไปเป็นสัตว์มีกระดูกสันหลังประเภทกินหญ้าทั้งจาก สัตว์บ้าน ปศุสัตว์ และสัตว์ป่า เช่น วัว ควาย แพะ แกะ กวาง ละมั่ง ม้า
ทั่วไป แอนแทรก ไม่ใช่โรคที่ติดต่อแพร่กระจายได้ง่าย(Contagious disease) คือ ไม่ติดต่อทางลมหายใจ ไอ จาม หรือ การคลุกคลี (เช่น ในโรคหวัดหรือโรคไข้หวัดใหญ่) แต่ติดต่อจาก
- ทางบาดแผล จากแผลได้รับเชื้อแอนแทรกที่เชื้อต้องอยู่ในรูปแบบสปอร์(Spore)ที่เรียกว่า Endospore
- หรือจากทางการสูดดม(Inhalation)
- หรือจากกินอาหารที่ติดเชื้อนี้ หรือ
- จากแผลการฉีดยาเสพติดผิดกฎหมาย
แอนแทรกในสัตว์: พบบ่อยในประเทศที่ยังไม่พัฒนาหรือที่กำลังพัฒนาที่การปศุสัตว์ยังไม่ดีพอ ไม่มีการฉีดวัคซีนสัตว์เพื่อป้องกันโรคนี้ เช่น อัฟริกา ปากีสถาน อเมริกากลาง อเมริกาใต้ เอเชียกลาง เอเชียตะวันตก และยุโรปตะวันออก
อนึ่ง: แอนแทรก มาจาก’ภาษากรีก’ หมายถึง ถ่านหิน เพราะเมื่อติดเชื้อที่ผิวหนังรอยโรคจะมีขนาดใหญ่ที่เป็นสีดำเหมือนสีถ่านหิน
แอนแทรกติดต่ออย่างไร? มีกลไกเกิดโรคอย่างไร?
แอนแทรก เป็นแบคทีเรียที่เกิดตามธรรมชาติอยู่ในดิน โดยจะอยู่ในรูปแบบของสปอร์ที่คง ทนต่อสภาพอากาศและต่อสิ่งแวดล้อม เชื้อในรูปแบบสปอร์มีชีวิตได้นานเป็นปีถึงสิบๆปี มีรายงานได้ถึง70 ปี
สปอร์แอนแทรกนี้ถ้าอยู่ภายนอกร่างกายของ คน สัตว์ จะไม่ก่อโรค ต่อ เมื่อเข้าสู่ร่างกายคน สัตว์ จึงจะก่อโรคได้ โดยสปอร์จะถูกร่างกายเปลี่ยนให้เป็นเชื้อแอนแทรกที่เจริญเติบโตและแบ่งตัวเพิ่มปริมาณได้อย่างรวดเร็ว แพร่กระจายเข้าสู่อวัยวะต่างๆทางกระแสเลือดและทางระบบน้ำเหลือง และสร้างสารพิษที่เรียกว่า’สารชีวพิษ (Biotoxin)’ซึ่งจะทำลายเซลล์ของเนื้อเยื่อ/อวัยวะต่างๆทั่วร่างกายที่ก่อให้เกิดการอักเสบรุนแรงของเนื้อเยื่อ/อวัยวะเหล่านั้นอย่างรุนแรง เกิด อาการบวม, มีของเหลว/น้ำจากเลือดซึมออกจากหลอดเลือดเข้ามาอยู่ในเนื้อเยื่อ เกิดภาวะเนื้อเยื่อเสียน้ำอย่างรุนแรง ร่วมกับมีเลือดออกในอวัยวะที่ติดเชื้อ ส่งผลให้เกิดภาวะช็อกรุนแรงและเกิดเนื้อตายเฉพาะส่วน (Necrosis)ของเนื้อเยื่อที่ขาดเลือด จนส่งผลให้ถึงผู้ป่วย/ผู้ติดเชื้อตายได้
อนึ่งสัตว์: ได้รับเชื้อแอนแทรกจากการกินหญ้าและสัมผัสดินที่มีสปอร์แอนแทรกอยู่
การติดเชื้อในคน:
คนติดเชื้อแอนแทรกจาก
- มีบาดแผลที่ผิวหนังและแผลสัมผัสกับสัตว์ป่วยโรคแอนแทรก ที่มักเป็นจากซากสัตว์ที่ตาย เพราะในภาวะนี้เชื้อแอนแทรกจะสร้างสปอร์ที่เป็นตัวก่อการติดต่อ และรวมถึงจากการสัมผัส หนังสัตว์ เขาสัตว์ ขนสัตว์ (รวมถึงการหายใจเอาขนสัตว์ป่วยเข้าสู่ร่างกาย) หรือ
- จากกินเนื้อสัตว์ป่วย
- และ/หรือจาก สูดดมสปอร์เชื้อฯ เช่น ในการทำงานในอุตสาหกรรมต่างๆที่เกี่ยวข้องกับสัตว์ หนังสัตว์ ขนสัตว์ เขาสัตว์
นอกจากนั้น ที่พบได้น้อย คือ
- จากการฉีด(เข้ากล้ามเนื้อ)สารเสพติดผิดกฎหมายที่เข็มติดเชื้อนี้ที่อยู่ในรูปสปอร์
- *และเนื่องจากสปอร์จากแอนแทรกมีชีวิตอยู่ได้นานและโรคก่ออาการรุนแรง จึงมีบางประเทศนำมาผลิตเป็นอาวุธสงครามชีวภาพ (Bioterrorism) ซึ่งก่อการติดเชื้อได้รุนแรงถึงตาย เช่น
- จากการสัมผัสจดหมายและ/หรือสิ่งของทางไปรษณีย์
- สูดดม และ
- ดื่มน้ำที่ปนเปื้อนสปอร์เหล่านี้
***อนึ่ง: ยังไม่มีรายงานโรคแอนแทรกติดต่อจากคนสู่คน
ใครมีปัจจัยเสี่ยงติดเชื้อแอนแทรก?
ผู้มีปัจจัยเสี่ยงติดเชื้อแอนแทรกได้แก่
- ทำงานในปศุสัตว์ เลี้ยงสัตว์ กลุ่มกินหญ้า
- ทำงานในอุตสาหกรรมที่เกี่ยวกับสัตว์กินหญ้า เช่น หนัง ขน กระดูก (ในสหรัฐอเมริกามีรายงานติดต่อจากการตีกลองที่ทำจากหนังสัตว์ที่ติดเชื้อนี้)
- ทำงานในห้องปฏิบัติการที่ศึกษาเกี่ยวกับเชื้อนี้
- เจ้าหน้าที่ไปรษณีย์ในประเทศที่มีการก่อการร้าย
- สัตวแพทย์ที่ดูแลสัตว์กลุ่มนี้
- ทหารที่ทำสงครามกับประเทศที่ใช้อาวุธชีวภาพ
- ผู้ฉีด (เข้ากล้ามเนื้อ)สารเสพติดผิดกฏหมายจากเข็มไม่สะอาดที่มีเชื้อนี้
แอนแทรกมีอาการอย่างไร?
เมื่อสปอร์แอนแทรกเข้าสู่ร่างกาย มักมีระยะฟักตัวประมาณ 1 - 7 วันแต่อาจนานได้ถึง 60 วันจึงก่อให้เกิดอาการ ทั้งนี้การติดเชื้อแอนแทรกมีได้ 4 รูปแบบคือ ผ่านทางผิวหนัง, ติด ทางระบบทางเดินอาหาร, ติดเชื้อจากการสูดดม, และติดเชื้อจากการฉีดสารเสพติดเข้ากล้ามเนื้อ ซึ่งอาการโรคจะขึ้นกับว่าเป็นการติดเชื้อจากวิธีใด
ก. การติดเชื้อทางผิวหนัง (Cutaneous anthrax): เกิดจากผิวหนังของคนที่มีแผลสัมผัสเชื้อนี้ที่อยู่ในรูปแบบสปอร์จึงก่อการติดเชื้อที่ผิวหนัง อาการที่พบได้ เช่น
- ผิวหนังที่ติดเชื้อมีลักษณะเป็นผื่นนูน คัน แต่ไม่เจ็บ
- ต่อมาจะเปลี่ยนเป็นตุ่มพองแล้วแตกเป็นแผลเปื่อย
- ซึ่งเมื่อแผลแตกเปื่อยจะเกิดเป็นสะเก็ดสีดำ (Eschar) และเกิดเป็นแผลเนื้อเน่าตายได้
ทั้งนี้การติดเชื้อทางผิวหนัง เป็นการติดเชื้อที่พบบ่อยที่สุดในการติดเชื้อแอนแทรกและเป็นชนิดที่มีความรุนแรงน้อย มักรักษาได้หายทุกราย แต่ถ้าโรครุนแรงมากจนลุกลามเป็นภาวะติดเชื้อในกระแสเลือด/ภาวะพิษเหตุติดเชื้อ มีรายงานอัตราตายประมาณ 20%
ข. การติดเชื้อทางระบบทางเดินอาหาร (Gastrointestinal and oropharyngeal anthrax): มักเกิดจากบริโภคเนื้อสัตว์ที่ติดโรค โดยอาการ เช่น
- มีไข้ หนาวสั่น
- ใบหน้าแดง
- ตาแดง
- ปวดหัว
- คลื่นไส้อาเจียน
- เจ็บคอ/คออักเสบ เจ็บเวลากลืน
- เสียงแหบ
- มีเสมหะเป็นเลือด
- ปวดท้อง
- ท้องเสีย อาจท้องเสียรุนแรง
- อุจจาระเป็นเลือด
- อ่อนเพลีย
- เป็นลม หมดสติ
*อนึ่ง: การติดเชื้อเข้าทางระบบทางเดินอาหาร พบน้อยแต่เป็นการติดเชื้อที่รุนแรง โดยมีรายงานอัตราตายประมาณ 25 - 70%
ค. การติดเชื้อจากการสูดดม (Inhalation anthrax): เกิดจากสูดดมเอาสปอร์ของเชื้อนี้เข้าสู่ปอด อาการ เช่น
- อาการคล้ายเป็นไข้หวัดใหญ่ (โรคคล้ายไข้หวัดใหญ่) เช่น ปวดเมื่อยเนื้อตัว มีไข้ หนาวสั่น ปวดหัว เจ็บคอ
- หายใจลำบาก/หอบเหนื่อย
- ไอเป็นเลือด
- คอแข็ง
- ภาวะช็อก
*อนึ่ง: การติดเชื้อทางการสูดดมมักรุนแรง มีรายงานอัตราตายสูงถึงประมาณ 90%เมื่อ ได้รับการรักษาล่าช้า แต่ถ้าได้รับยาปฏิชีวนะทันท่วงที่ตั้งแต่ระยะแรกติดเชื้อ มีรายงานอัตราตายประมาณ 80%
ง. การติดเชื้อจากการฉีด (เข้ากล้ามเนื้อ) สารเสพติดผิดกฎหมาย (Injection anthrax): เป็นการติดเชื้อที่เพิ่งมีรายงานเกิดในยุโรปเหนือเมื่อ ค.ศ. 2009 (พ.ศ. 2552) โดย อาการจะเหมือนกับการติดเชื้อทางผิวหนังแต่จะรุนแรงกว่า เพราะเกิดการติดเชื้อในกล้ามเนื้อส่วนที่อยู่ลึกซึ่งตำแหน่งรอยโรคจะบวมมาก แดง เกิดเป็นฝีหนอง และร่วมกับมีอาการอื่นๆ เช่น มีไข้ หนาวสั่น ซึ่งโรคอาจลุกลามเป็นภาวะติดเชื้อในกระแสเลือด และมีรายงานอัตราตายประมาณ 30%
***อนึ่ง: แอนแทรกทุกรูปแบบถ้ารักษาล่าช้าหรือไม่ได้รับการรักษา โรคจะลุกลามแพร่กระจายรุนแรงเข้าสู่กระแสเลือดเกิดภาวะติดเชื้อในกระแสเลือด ผ่านเข้าสู่เยื่อหุ้มสมอง เนื้อสมอง ส่งผลมีอาการทางสมองได้ และผู้ป่วยมักเกิดภาวะช็อกอย่างรุนแรงและถึงตายในที่สุด
ควรพบแพทย์เมื่อไหร่?
ผู้สัมผัสสัตว์/ผลิตภัณฑ์สัตว์กินหญ้าและผู้มีปัจจัยเสี่ยงดังกล่าวใน’หัวข้อ ปัจจัยเสี่ยงฯ’ ควรรีบพบแพทย์/ไปโรงพยาบาลเสมอเมื่อสงสัยการติดโรคนี้หรือมีอาการดังกล่าวใน’หัวข้ออาการฯ’
แพทย์วินิจฉัยแอนแทรกได้อย่างไร?
แพทย์วินิจฉัยโรคแอนแทรกได้จาก
- ประวัติอาการต่างๆ ประวัติการสัมผัสสัตว์กินหญ้า อาชีพ/การงาน ประวัติปัจจัยเสี่ยง
- การตรวจร่างกาย
- การตรวจเชื้อ และ/หรือการเพาะเชื้อจาก เลือด ปัสสาวะ อุจจาระ และ/หรือจากน้ำในโพรงสมองและไขสันหลัง/ซีเอสเอฟ/CSF
- ตรวจเลือด ดู สารภูมิต้านทาน และ/หรือ สารก่อภูมิต้านทานต่อโรคนี้
- ตรวจภาพอวัยวะที่มีอาการด้วยเอกซเรย์และ/หรือเอกซเรย์คอมพิวเตอร์(ซีทีสแกน)
- ในผู้ป่วยบางรายโดยเฉพาะผู้ที่มีรอยโรคที่ผิวหนัง แพทย์อาจตัดชิ้นเนื้อจากรอยโรคเพื่อการตรวจทางพยาธิวิทยา
รักษาแอนแทรกอย่างไร?
การรักษาแอนแทรกประกอบด้วยการให้ยาปฏิชีวนะและการรักษาตามอาการ
ก. การให้ยาปฏิชีวนะ: จะได้ผลดีกว่าเมื่อเริ่มให้ยาตั้งแต่รู้ว่าสัมผัสโรคโดยยังไม่เกิด อาการ เรียกว่า เป็นการรักษาแบบป้องกัน แต่เมื่อมีอาการแล้วการรักษาได้ผลไม่ดีเท่าที่ควร และผู้ป่วยอาจมีอัตราตายได้สูง
ซึ่งยาปฏิชีวนะที่ใช้รักษาโรคนี้มีหลายตัว โดยการรักษาอาจใช้ยาฯเพียงตัวเดียวหรือหลายตัวร่วมกันทั้งนี้ขึ้นกับความรุนแรงของโรคและดุลพินิจของแพทย์ เช่น ยา Cyprofloxacin, Doxycycline, Erythromycin, Penicillin
ข. การรักษาตามอาการ: เช่น การให้สารน้ำทางหลอดเลือดดำกรณีกินอาหารได้น้อย, การให้ออกซิเจนกรณีมีอาการทางการหายใจ, การให้เลือดถ้ามีภาวะซีดจากเลือดออกมาก, รวมไปถึงการให้ยาแก้อักเสบในกลุ่มสเตียรอยด์
อนึ่ง ปัจจุบันได้มีการศึกษานำยาที่เป็นสารภูมิต้านทาน/ โมโนโคลนอลแอนตีบอดี (Monoclonal antibody therapy) เช่น ยา Raxibacumab มาใช้ทั้งในการป้องกันและในการรักษาการติดเชื้อแอนแทรกจากการสูดดม ซึ่งได้ผลดีในระดับหนึ่ง
แอนแทรกก่อผลข้างเคียงอย่างไร?
ผลข้างเคียงสำคัญจากการติดเชื้อแอนแทรกคือ
- เกิดอักเสบรุนแรงต่อทุกอวัยวะ โดยเฉพาะต่อสมอง และการเกิดภาวะช็อกรุนแรงจนเป็นเหตุถึงตายในที่สุด
ดูแลตนเองอย่างไร?
การดูแลตนเองเมื่อมีการติดเชื้อแอนแทรก คือ
- ปฏิบัติตามแพทย์พยาบาลแนะนำอย่างเคร่งครัด โดยทั่วไปแพทย์มักรับตัวผู้ติดเชื้อแอนแทรกไว้รักษาในโรงพยาบาล
- ซึ่งเมื่อแพทย์ให้กลับบ้านได้ ต้องกินยาต่างๆที่แพทย์สั่งอย่างถูกต้องครบถ้วน ไม่ขาดยา เพราะดังกล่าวแล้วในตอนต้น‘หัวข้อ อาการฯ’ว่า สปอร์ของแอนแทรกสามารถมีชีวิตอยู่ได้เป็นระยะเวลายาวนาน
นอกจากนั้นการดูแลตนเองอื่นๆ เช่น
- พบแพทย์/ไปโรงพยาบาลตามนัดเสมอ
- พบแพทย์/ไปโรงพยาบาลก่อนนัดเสมอเมื่อ
- อาการต่างๆแย่ลง
- มีอาการใหม่ที่ผิดไปจากเดิม
- มีผลข้างเคียงอย่างต่อเนื่องจากยาที่แพทย์สั่งจนกระทบต่อการใช้ชีวิตประจำวัน เช่น คลื่นไส้อาเจียน ท้องผูก หรือ ท้องเสีย
- กังวลในอาการ
ป้องกันแอนแทรกได้อย่างไร?
การป้องกันติดเชื้อแอนแทรก คือ
- หลีกเลี่ยงการสัมผัส คลุกคลี ใกล้ชิด สัตว์กินหญ้า
- ผู้ที่เลี้ยงสัตว์กินหญ้า ต้องดูแลสัตว์และฉีดวัคซีนป้องกันเชื้อแอนแทรกให้สัตว์ตามคำแนะนำของกรมปศุสัตว์ รวมทั้ง
- ต้องรู้จักดูแลตนเองในการกำจัดซากสัตว์กินหญ้าที่ตายด้วยเชื้อแอนแทรกและ/หรือที่ตายโดยไม่ทราบสาเหตุ
อนึ่ง:
- ในคนมีวัคซีนป้องกันการติดเชื้อแอนแทรกเช่นกันทั้งชนิดเป็นเชื้อแอนแทรกที่ทำให้อ่อนฤทธิ์ (วัคซีนเชื้อเป็น/Live vaccine) และชนิดผลิตจากชิ้นส่วนของเชื้อแอนแทรก (Acellular vaccine)ที่ช่วยลดผลข้างเคียงจากวัคซีนลงได้มากกว่าวัคซีนเชื้อเป็น
- วัคซีนนี้มีข้อห้ามคือ ห้ามฉีดในหญิงตั้งครรภ์
*อย่างไรก็ตาม จากเป็นโรคพบน้อยและวัคซีนมีผลข้างเคียงค่อนข้างสูง เช่น ไข้สูง หนาวสั่น สับสน ชัก หายใจลำบาก ตำแหน่งที่ฉีดวัคซีนบวม แดง อักเสบ จึงยังไม่มีการแนะนำฉีดวัคซีนในคนทั่วไป โดยจะฉีดป้องกันเฉพาะกลุ่มคนปัจจัยเสี่ยงสูง(กล่าวใน’หัวข้อ ผู้มีปัจจัยเสี่ยงติดโรคฯ’)ที่จะติดโรคนี้เท่านั้น
บรรณานุกรม
- Dixon,T., et al. (1999).Anthrax. NEJM. 341,815-826.
- O’Brien,K. et al. (2003). Regcognition and management of bioterrorism. Am Fam Physician. 67,1927-1934
- https://en.wikipedia.org/wiki/Anthrax [2022,June25]
- https://www.cdc.gov/anthrax/basics/index.html [2022,June25]
- https://www.cdc.gov/anthrax/prevention/index.html?CDC_AA_refVal=https%3A%2F%2Fwww.cdc.gov%2Fanthrax%2Fmedical-care%2Fprevention.html [2022,June25]
- https://medlineplus.gov/druginfo/meds/a607013.html [2022,June25]
- https://pubmed.ncbi.nlm.nih.gov/23267409/ [2022,June25]
- https://www.healthline.com/health/zoonosis#types [2022,June25]
- https://www.fda.gov/vaccines-blood-biologics/vaccines/anthrax [2022,June25]


